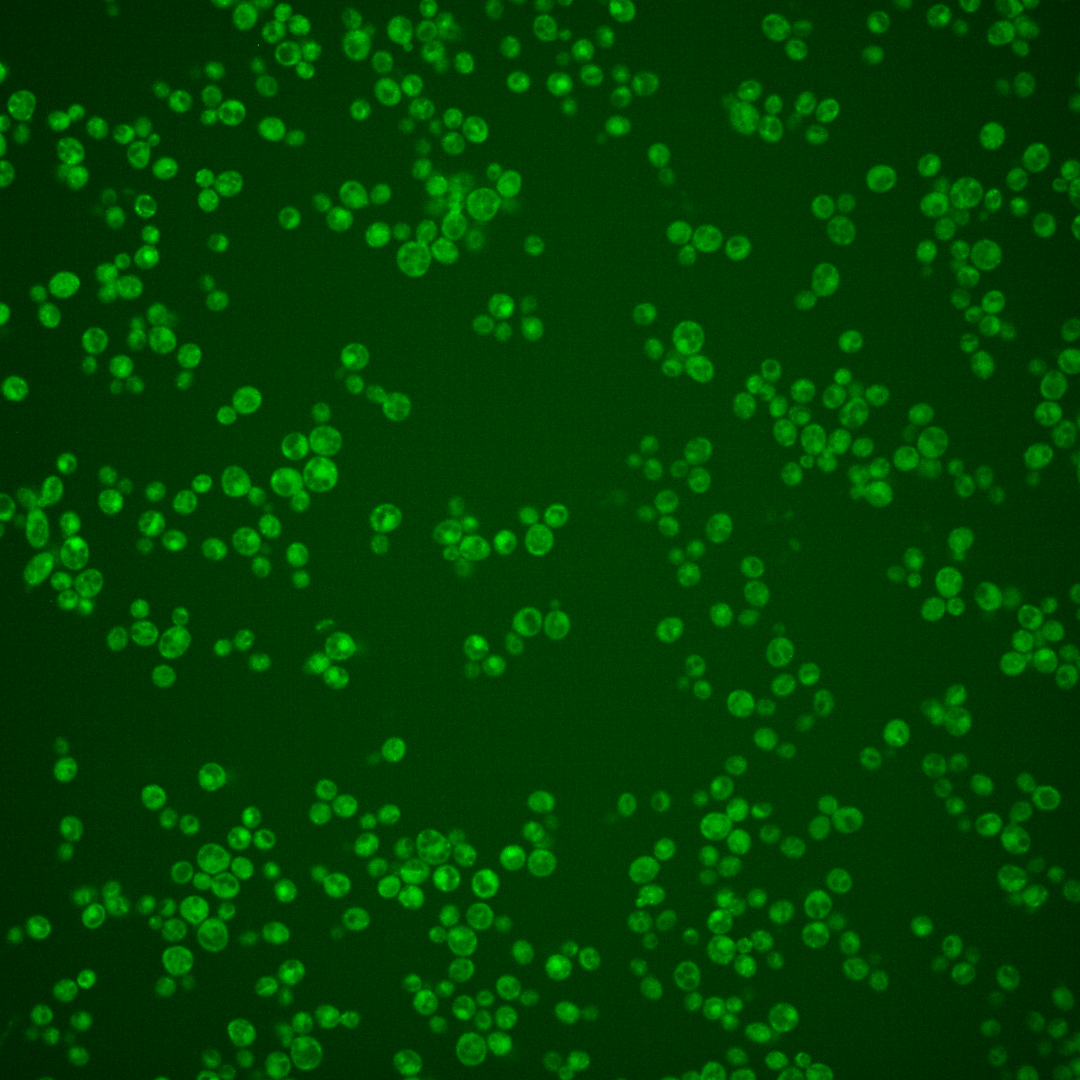
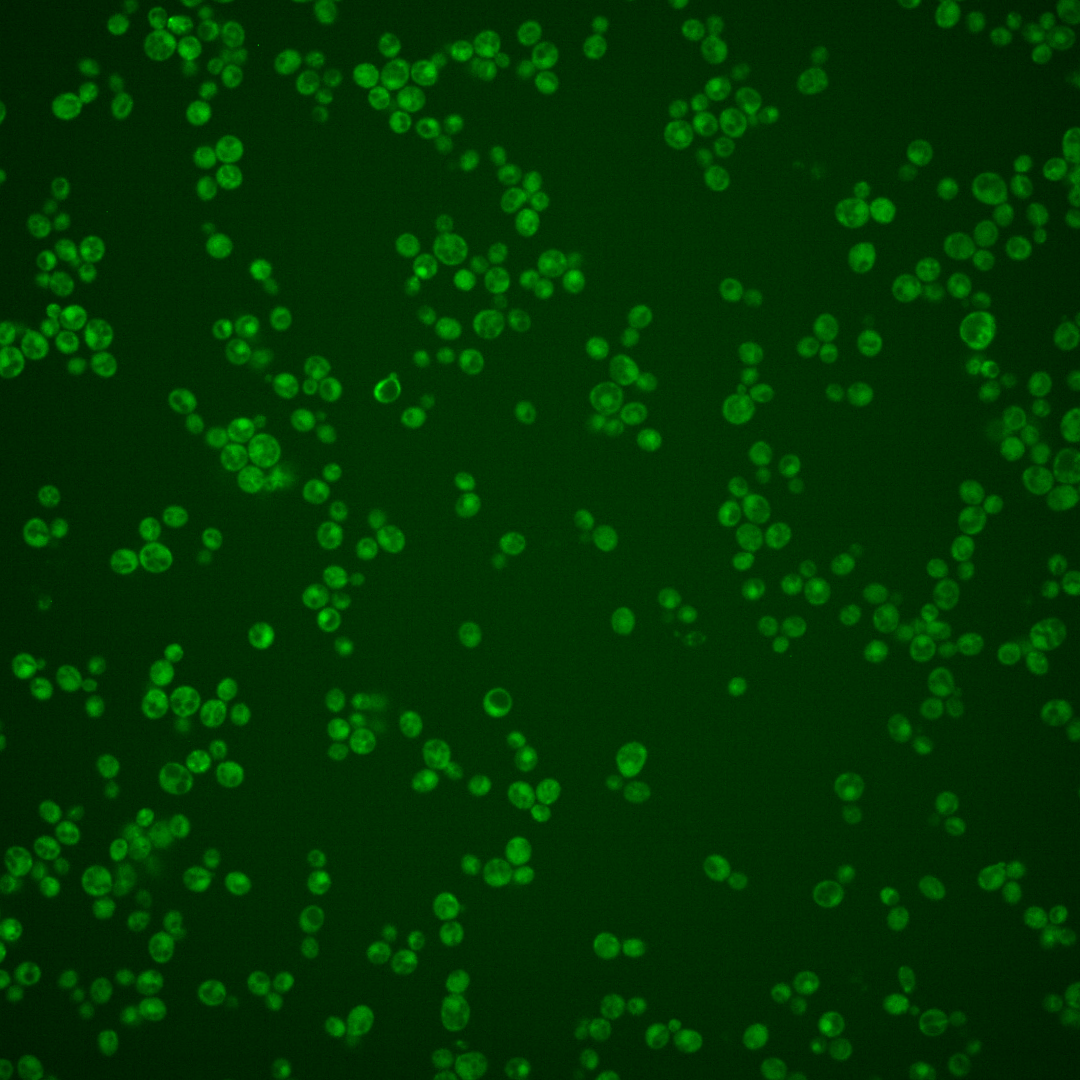
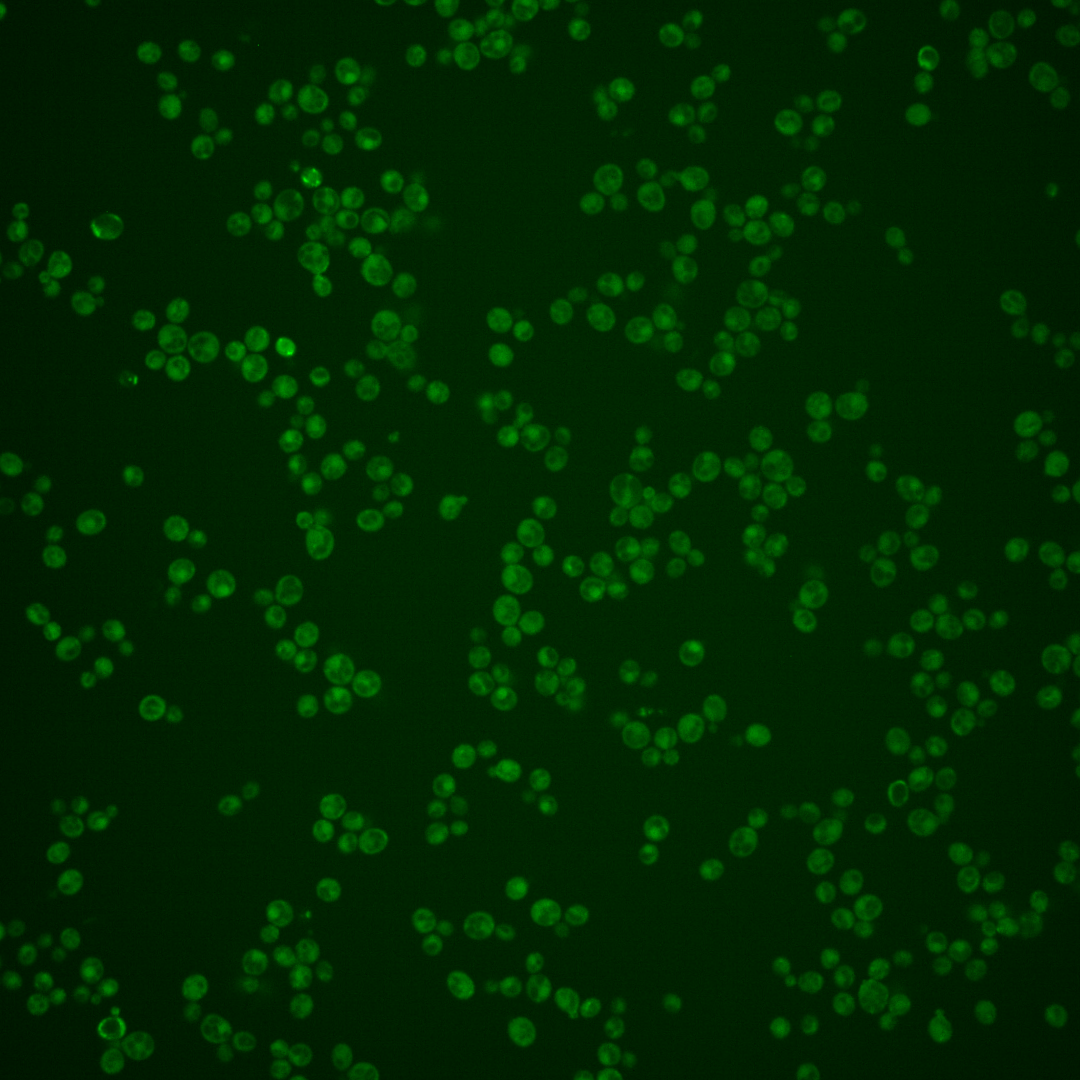
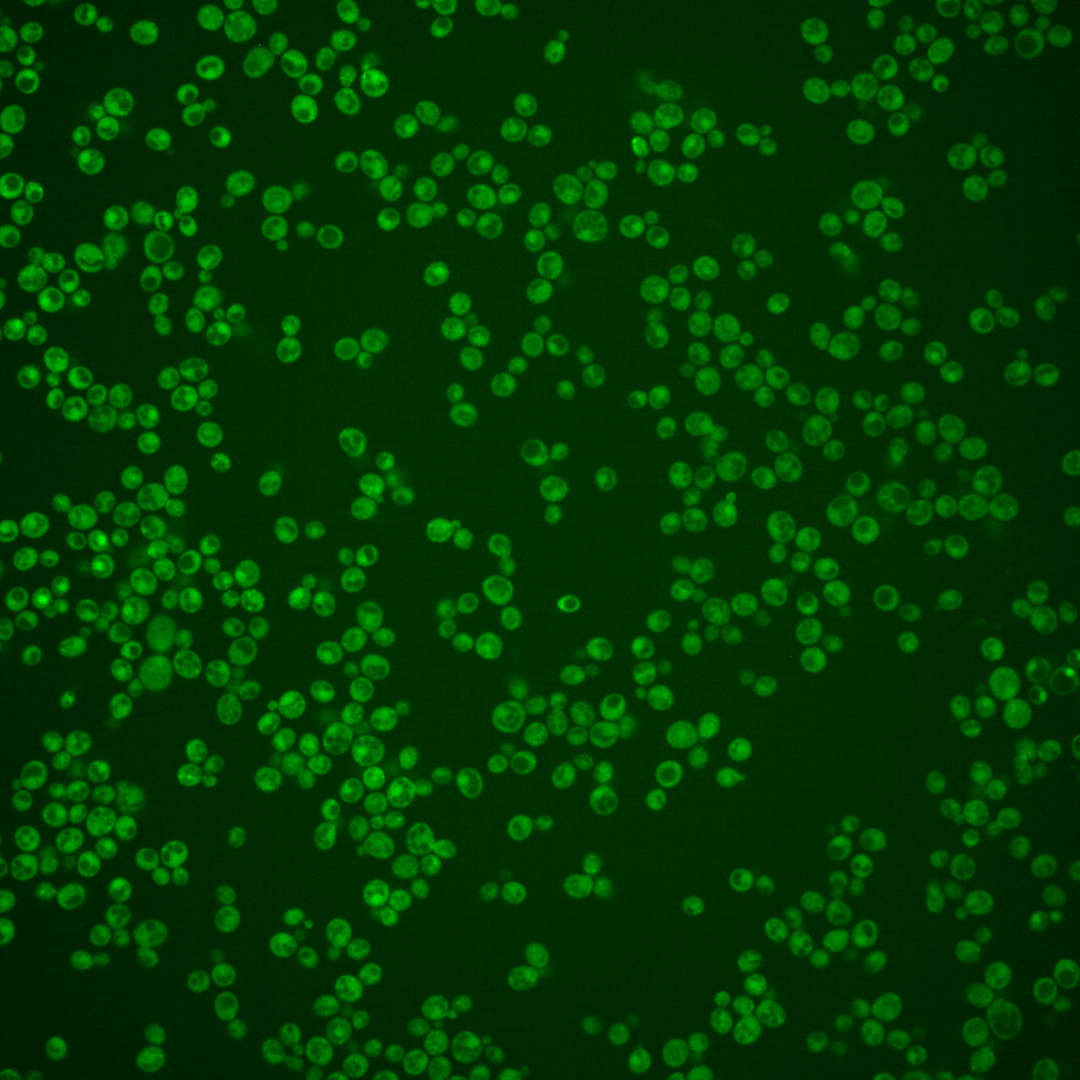
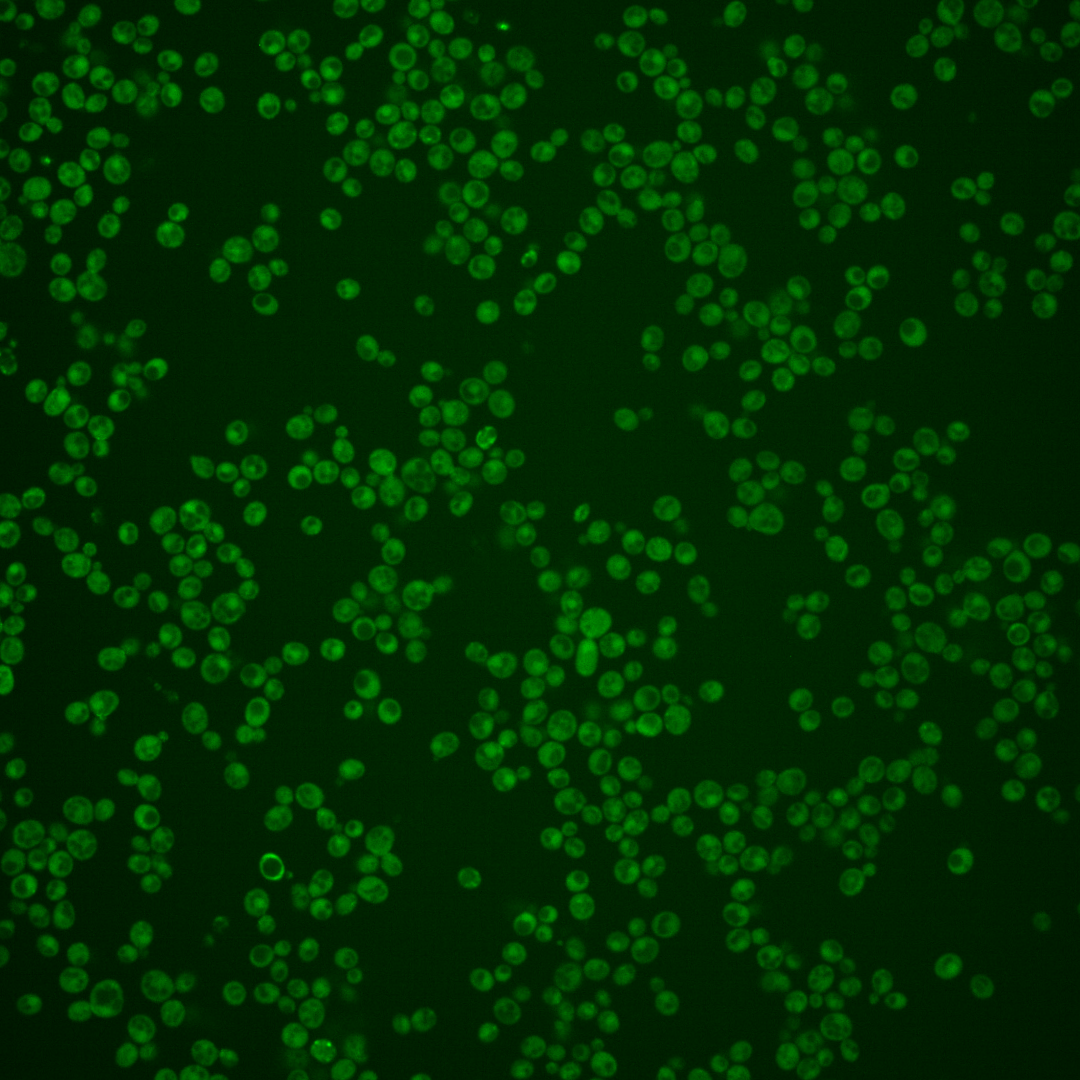
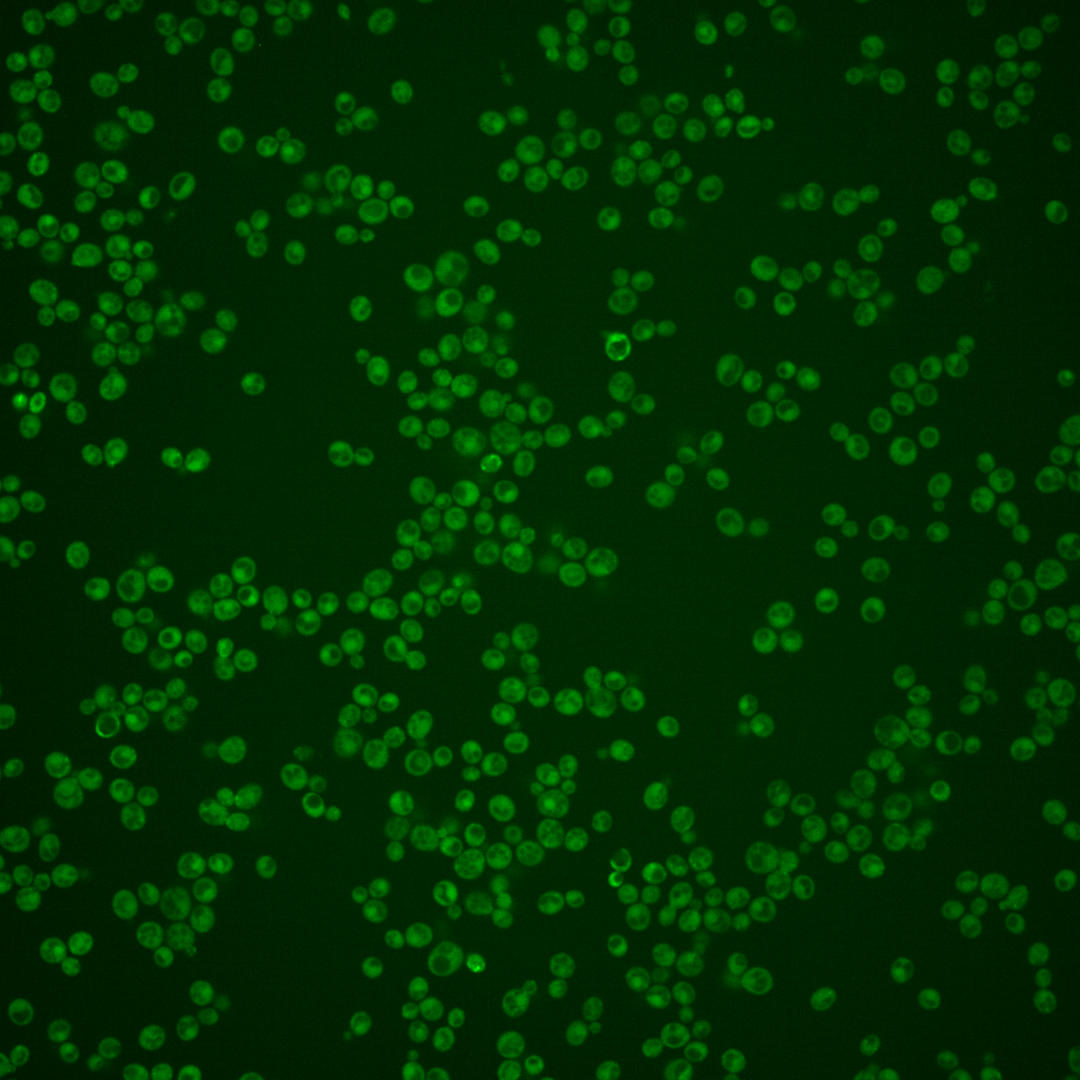

| ORF | |
|---|---|
| Human Ortholog | |
| Description | Potential noncatalytic subunit for phospholipid translocase Dnf3p; YNR048W has a paralog, CDC50, that arose from the whole genome duplication |
Micrographs




















































































Sub-cellular Localization
Yeast GFP Assignment
Protein Abundance
Localization Change
External localization resources
| ensLOC | DeepLoc | |||||||||||||||||||||||
|---|---|---|---|---|---|---|---|---|---|---|---|---|---|---|---|---|---|---|---|---|---|---|---|---|
| Localization | WT1 | WT2 | WT3 | RAP60 | RAP140 | RAP220 | RAP300 | RAP380 | RAP460 | RAP540 | RAP620 | RAP700 | HU80 | HU120 | HU160 | rpd3Δ_1 | rpd3Δ_2 | rpd3Δ_3 | WT1 | WT2 | WT3 | AF100 | AF140 | AF180 |
| Cortical Patches | 3 | 17 | 13 | 6 | 4 | 1 | 3 | 1 | 4 | 4 | 1 | 1 | 3 | 0 | 0 | 31 | 25 | 24 | 12 | 18 | 53 | 20 | 23 | 32 |
| Bud | 0 | 8 | 9 | 7 | 5 | 15 | 25 | 12 | 17 | 14 | 12 | 11 | 1 | 0 | 2 | 3 | 8 | 8 | 6 | 11 | 12 | 17 | 11 | 22 |
| Bud Neck | 0 | 0 | 1 | 1 | 0 | 0 | 4 | 0 | 0 | 0 | 1 | 1 | 1 | 1 | 1 | 0 | 3 | 0 | 5 | 8 | 16 | 18 | 17 | 18 |
| Bud Site | 0 | 0 | 1 | 0 | 2 | 8 | 2 | 2 | 1 | 5 | 1 | 3 | 0 | 0 | 0 | 0 | 0 | 0 | – | – | – | – | – | – |
| Cell Periphery | 0 | 1 | 5 | 3 | 3 | 1 | 5 | 4 | 0 | 2 | 2 | 2 | 1 | 1 | 1 | 8 | 15 | 12 | 0 | 2 | 6 | 2 | 4 | 5 |
| Cytoplasm | 96 | 173 | 205 | 141 | 156 | 255 | 293 | 189 | 192 | 186 | 122 | 148 | 261 | 214 | 282 | 130 | 187 | 152 | 47 | 127 | 93 | 82 | 108 | 116 |
| Endoplasmic Reticulum | 5 | 12 | 14 | 4 | 1 | 3 | 4 | 1 | 9 | 4 | 4 | 5 | 3 | 5 | 2 | 7 | 13 | 12 | 5 | 7 | 19 | 1 | 2 | 5 |
| Endosome | 1 | 2 | 5 | 1 | 5 | 4 | 1 | 4 | 1 | 0 | 2 | 0 | 3 | 1 | 4 | 3 | 8 | 17 | 8 | 10 | 13 | 5 | 5 | 4 |
| Golgi | 0 | 0 | 1 | 0 | 0 | 0 | 0 | 0 | 0 | 0 | 0 | 0 | 0 | 0 | 0 | 0 | 0 | 0 | 2 | 2 | 5 | 1 | 1 | 1 |
| Mitochondria | 25 | 3 | 23 | 15 | 7 | 96 | 168 | 140 | 143 | 121 | 144 | 143 | 0 | 0 | 0 | 7 | 10 | 4 | 28 | 27 | 77 | 22 | 26 | 16 |
| Nucleus | 0 | 0 | 0 | 0 | 1 | 2 | 2 | 0 | 0 | 1 | 2 | 0 | 0 | 0 | 0 | 3 | 2 | 1 | 0 | 0 | 0 | 1 | 1 | 1 |
| Nuclear Periphery | 0 | 0 | 0 | 0 | 0 | 0 | 0 | 0 | 0 | 0 | 0 | 1 | 0 | 0 | 0 | 0 | 0 | 1 | 0 | 0 | 0 | 0 | 0 | 0 |
| Nucleolus | 0 | 0 | 0 | 0 | 0 | 1 | 0 | 0 | 0 | 0 | 2 | 1 | 0 | 0 | 0 | 0 | 0 | 0 | 0 | 0 | 0 | 0 | 0 | 0 |
| Peroxisomes | 0 | 0 | 1 | 1 | 3 | 1 | 0 | 2 | 0 | 0 | 0 | 0 | 1 | 0 | 6 | 0 | 0 | 3 | 0 | 0 | 1 | 0 | 0 | 0 |
| SpindlePole | 0 | 2 | 3 | 4 | 5 | 5 | 6 | 9 | 3 | 2 | 1 | 2 | 4 | 0 | 3 | 7 | 9 | 7 | 0 | 2 | 2 | 4 | 2 | 1 |
| Vac/Vac Membrane | 0 | 1 | 1 | 0 | 3 | 0 | 2 | 6 | 3 | 2 | 4 | 1 | 1 | 2 | 4 | 7 | 7 | 12 | 9 | 16 | 11 | 10 | 10 | 10 |
| Unique Cell Count | 123 | 204 | 259 | 166 | 179 | 326 | 420 | 309 | 298 | 284 | 235 | 253 | 274 | 218 | 297 | 182 | 253 | 219 | 128 | 239 | 319 | 193 | 219 | 238 |
| Labelled Cell Count | 130 | 219 | 282 | 183 | 195 | 392 | 515 | 370 | 373 | 341 | 298 | 319 | 279 | 224 | 305 | 206 | 287 | 253 | 128 | 239 | 319 | 193 | 219 | 238 |
Yeast GFP Assignment
Protein Abundance
| Screen | WT1 | WT2 | WT3 | RAP60 | RAP140 | RAP220 | RAP300 | RAP380 | RAP460 | RAP540 | RAP620 | RAP700 | HU80 | HU120 | HU160 | rpd3Δ_1 | rpd3Δ_2 | rpd3Δ_3 | AF100 | AF140 | AF180 |
|---|---|---|---|---|---|---|---|---|---|---|---|---|---|---|---|---|---|---|---|---|---|
| Mean Cell GFP Intensity (1e-4) | 3.9 | 4.7 | 4.2 | 4.0 | 6.2 | 3.7 | 3.5 | 3.4 | 3.4 | 3.3 | 3.0 | 3.0 | 5.5 | 5.6 | 5.4 | 7.4 | 7.1 | 6.6 | 5.5 | 5.5 | 5.9 |
| Std Deviation (1e-4) | 0.7 | 1.0 | 0.9 | 1.5 | 6.6 | 1.6 | 1.4 | 1.3 | 1.3 | 0.8 | 1.1 | 0.8 | 1.1 | 1.1 | 1.5 | 1.0 | 1.3 | 1.1 | 1.3 | 1.6 | 1.7 |
| Intensity Change (Log2) | – | – | – | -0.07 | 0.56 | -0.17 | -0.27 | -0.29 | -0.29 | -0.34 | -0.5 | -0.48 | 0.4 | 0.41 | 0.37 | 0.82 | 0.76 | 0.65 | 0.39 | 0.4 | 0.49 |
Localization Change
| Localization | RAP60 | RAP140 | RAP220 | RAP300 | RAP380 | RAP460 | RAP540 | RAP620 | RAP700 | HU80 | HU120 | HU160 | rpd3Δ_1 | rpd3Δ_2 | rpd3Δ_3 |
|---|---|---|---|---|---|---|---|---|---|---|---|---|---|---|---|
| Actin | – | – | – | – | – | – | – | – | – | – | – | – | – | – | – |
| Bud | – | – | – | – | – | – | – | – | – | – | – | – | – | – | 0 |
| Bud Neck | – | – | – | – | – | – | – | – | – | – | – | – | – | – | 0 |
| Bud Site | – | – | – | – | – | – | – | – | – | – | – | – | – | – | 0 |
| Cell Periphery | – | – | – | – | – | – | – | – | – | – | – | – | – | – | 0 |
| Cyto | – | – | – | – | – | – | – | – | – | – | – | – | – | – | – |
| Endoplasmic Reticulum | – | – | – | – | – | – | – | – | – | – | – | – | – | – | 0 |
| Endosome | – | – | – | – | – | – | – | – | – | – | – | – | – | – | 0 |
| Golgi | – | – | – | – | – | – | – | – | – | – | – | – | – | – | 0 |
| Mitochondria | – | – | – | – | – | – | – | – | – | – | – | – | – | – | 0 |
| Nuclear Periphery | – | – | – | – | – | – | – | – | – | – | – | – | – | – | 0 |
| Nuc | – | – | – | – | – | – | – | – | – | – | – | – | – | – | – |
| Nucleolus | – | – | – | – | – | – | – | – | – | – | – | – | – | – | 0 |
| Peroxisomes | – | – | – | – | – | – | – | – | – | – | – | – | – | – | 0 |
| SpindlePole | – | – | – | – | – | – | – | – | – | – | – | – | – | – | 0 |
| Vac | – | – | – | – | – | – | – | – | – | – | – | – | – | – | – |
| Cortical Patches | – | – | – | – | – | – | – | – | – | – | – | – | – | – | 0 |
| Cytoplasm | – | – | – | – | – | – | – | – | – | – | – | – | – | – | 0 |
| Nucleus | – | – | – | – | – | – | – | – | – | – | – | – | – | – | 0 |
| Vacuole | – | – | – | – | – | – | – | – | – | – | – | – | – | – | 3.4 |
External localization resources
Images






























Protein Concentration and Protein Localization Data
| R1 | R2 | R3 | ||||||||||||||||
|---|---|---|---|---|---|---|---|---|---|---|---|---|---|---|---|---|---|---|
| G1 Pre-START | G1 Post-START | S/G2 | Metaphase | Anaphase | Telophase | G1 Pre-START | G1 Post-START | S/G2 | Metaphase | Anaphase | Telophase | G1 Pre-START | G1 Post-START | S/G2 | Metaphase | Anaphase | Telophase | |
| Concentration | 1.2907 | 0.1374 | 0.2149 | -0.2441 | -0.6304 | 0.2292 | 2.5921 | 0.1305 | 0.3917 | 0.0636 | 0.1137 | 0.2087 | 0.7889 | -0.0841 | -0.2992 | -0.3308 | -0.3614 | -0.1532 |
| Actin | 0.0758 | 0.0002 | 0.0045 | 0.0002 | 0.0006 | 0.0143 | 0.1524 | 0.0021 | 0.0087 | 0.0005 | 0.0059 | 0.0084 | 0.0557 | 0.0011 | 0.0117 | 0.0072 | 0.0049 | 0.0158 |
| Bud | 0.002 | 0.0004 | 0.0011 | 0 | 0 | 0.0002 | 0.0022 | 0.0032 | 0.0014 | 0.0001 | 0.0004 | 0.0003 | 0.0013 | 0.0026 | 0.0044 | 0.0002 | 0.0002 | 0.0017 |
| Bud Neck | 0.005 | 0.0005 | 0.0004 | 0 | 0.0001 | 0.0269 | 0.0121 | 0.0005 | 0.0029 | 0.0027 | 0.0016 | 0.0141 | 0.0073 | 0.0005 | 0.0016 | 0.0014 | 0.0002 | 0.0227 |
| Bud Periphery | 0.0044 | 0.0005 | 0.0021 | 0.0001 | 0 | 0.0005 | 0.003 | 0.0045 | 0.0021 | 0.0002 | 0.0007 | 0.0007 | 0.0017 | 0.0022 | 0.0076 | 0.0002 | 0.0004 | 0.0021 |
| Bud Site | 0.009 | 0.0115 | 0.0069 | 0 | 0 | 0.0004 | 0.0278 | 0.0104 | 0.0373 | 0.0007 | 0.0015 | 0.0003 | 0.0086 | 0.0242 | 0.0225 | 0.0007 | 0.0003 | 0.0021 |
| Cell Periphery | 0.0014 | 0.0003 | 0.0005 | 0 | 0 | 0.0004 | 0.0016 | 0.0004 | 0.0005 | 0.0001 | 0.0001 | 0.0001 | 0.0005 | 0.0003 | 0.0004 | 0.0001 | 0.0001 | 0.0003 |
| Cytoplasm | 0.0339 | 0.0805 | 0.0951 | 0.0895 | 0.1378 | 0.1196 | 0.1115 | 0.1132 | 0.1222 | 0.1292 | 0.1021 | 0.1975 | 0.181 | 0.1966 | 0.1851 | 0.0832 | 0.218 | 0.187 |
| Cytoplasmic Foci | 0.0419 | 0.0062 | 0.0236 | 0.0037 | 0.0023 | 0.0174 | 0.0982 | 0.0111 | 0.0198 | 0.052 | 0.0291 | 0.0078 | 0.054 | 0.0208 | 0.0281 | 0.0187 | 0.0109 | 0.0127 |
| Eisosomes | 0.004 | 0.0002 | 0.0002 | 0.0002 | 0.0002 | 0.0001 | 0.0012 | 0.0001 | 0.0001 | 0 | 0.0001 | 0 | 0.0005 | 0.0001 | 0.0002 | 0.0001 | 0.0003 | 0.0002 |
| Endoplasmic Reticulum | 0.0107 | 0.0013 | 0.005 | 0.0004 | 0.0007 | 0.0022 | 0.0131 | 0.0015 | 0.0021 | 0.0007 | 0.0022 | 0.0007 | 0.005 | 0.0014 | 0.0023 | 0.0019 | 0.004 | 0.0023 |
| Endosome | 0.0619 | 0.0022 | 0.018 | 0.0006 | 0.003 | 0.0103 | 0.0825 | 0.0122 | 0.0071 | 0.0223 | 0.0468 | 0.0013 | 0.0553 | 0.0102 | 0.0222 | 0.0113 | 0.0162 | 0.0142 |
| Golgi | 0.0236 | 0.0001 | 0.0023 | 0.0001 | 0.0001 | 0.003 | 0.032 | 0.0016 | 0.0022 | 0.002 | 0.0089 | 0.0005 | 0.0166 | 0.0006 | 0.0028 | 0.0018 | 0.0022 | 0.003 |
| Lipid Particles | 0.0608 | 0.0004 | 0.0159 | 0.0007 | 0.0003 | 0.0041 | 0.0323 | 0.0009 | 0.0093 | 0.0074 | 0.0325 | 0.0006 | 0.0264 | 0.0002 | 0.007 | 0.0047 | 0.0032 | 0.0034 |
| Mitochondria | 0.0421 | 0.0002 | 0.0037 | 0.0004 | 0.0003 | 0.0018 | 0.0136 | 0.0023 | 0.0136 | 0.003 | 0.0134 | 0.0003 | 0.0057 | 0.0007 | 0.0034 | 0.0011 | 0.0035 | 0.0017 |
| None | 0.4982 | 0.8898 | 0.8043 | 0.9025 | 0.8122 | 0.7696 | 0.2786 | 0.8302 | 0.7445 | 0.7288 | 0.6507 | 0.7544 | 0.5191 | 0.7266 | 0.6796 | 0.8269 | 0.7013 | 0.7083 |
| Nuclear Periphery | 0.0232 | 0.0004 | 0.0011 | 0.0003 | 0.0075 | 0.013 | 0.0294 | 0.0005 | 0.0025 | 0.0005 | 0.0085 | 0.0009 | 0.0075 | 0.0005 | 0.0023 | 0.0066 | 0.0237 | 0.0108 |
| Nucleolus | 0.0307 | 0.0008 | 0.0024 | 0.0001 | 0.002 | 0.0004 | 0.006 | 0.0003 | 0.0018 | 0.0005 | 0.0023 | 0.0004 | 0.0013 | 0.0004 | 0.0004 | 0.0022 | 0.0007 | 0.0005 |
| Nucleus | 0.0089 | 0.0007 | 0.0017 | 0.0002 | 0.015 | 0.003 | 0.0119 | 0.0008 | 0.0037 | 0.0026 | 0.0027 | 0.0023 | 0.003 | 0.002 | 0.003 | 0.0111 | 0.0029 | 0.0019 |
| Peroxisomes | 0.0247 | 0.0002 | 0.0064 | 0.0003 | 0.0001 | 0.0081 | 0.0438 | 0.0008 | 0.0077 | 0.0414 | 0.0436 | 0.0018 | 0.0264 | 0.0005 | 0.0109 | 0.0048 | 0.0005 | 0.0012 |
| Punctate Nuclear | 0.0247 | 0.0028 | 0.0024 | 0.0003 | 0.0168 | 0.003 | 0.0371 | 0.0006 | 0.009 | 0.0008 | 0.0409 | 0.0063 | 0.016 | 0.0015 | 0.0013 | 0.0106 | 0.002 | 0.0058 |
| Vacuole | 0.0089 | 0.0006 | 0.002 | 0.0003 | 0.0007 | 0.0008 | 0.0065 | 0.0025 | 0.0013 | 0.004 | 0.0035 | 0.001 | 0.0053 | 0.0066 | 0.0029 | 0.0043 | 0.002 | 0.0017 |
| Vacuole Periphery | 0.0041 | 0.0001 | 0.0004 | 0.0001 | 0.0002 | 0.001 | 0.0032 | 0.0004 | 0.0003 | 0.0004 | 0.0024 | 0.0002 | 0.002 | 0.0004 | 0.0005 | 0.0009 | 0.0026 | 0.0008 |
Sequencing Data
| R1 | R2 | |||||||||
|---|---|---|---|---|---|---|---|---|---|---|
| G1 Post-START | S/G2 | Metaphase | Anaphase | Telophase | G1 Post-START | S/G2 | Metaphase | Anaphase | Telophase | |
| Gene Expression | 18.6701 | 15.021 | 8.6693 | 12.4543 | 12.7085 | 11.1959 | 16.4533 | 10.2507 | 13.0796 | 13.4001 |
| Translational Efficiency | 0.4022 | 0.4331 | 0.7305 | 0.4117 | 0.6232 | 0.7876 | 0.444 | 0.6641 | 0.4834 | 0.6186 |
Hit Data
| Dataset | Hit |
|---|---|
| Protein Concentration | ✘ |
| Protein Localization | ✘ |
| Gene Expression | ✘ |
| Translational Efficiency | ✘ |
Endocytosis
| Temp | Actin Patch (Sac6-tdTomato) | Cortical Patch (Sla1-GFP) | Late Endosome (Snf7-GFP) | Vacuole (Vph1-GFP) |
|---|---|---|---|---|
| 37℃ | ||||
| RT |
Cell Cycle Omics
CYCLoPs (Ynr048w-GFP)
| Gene / Allele | Actin Patch (Sac6-tdTomato) | Cortical Patch (Sla1-GFP) | Late Endosome (Snf7-GFP) | Vacuole (Sac6-tdTomato) |
|---|
| Gene | Images |
|---|
| Gene | Images |
|---|
Images are not yet available
Images are not yet available